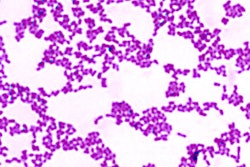

A better understanding of the role of pH in the oral cavity is the driving concept behind new oral health products arriving on the market.
BasicBites are sugar-free chews that mimic saliva's natural benefits. All images courtesy of Ortek Therapeutics.BasicBites, a sugar-free chew that mimics saliva's natural benefits, is one such product from Ortek Therapeutics that was released earlier in 2014. And Colgate has released a line of consumer products with "Sugar Acid Neutralizer Technology" in the U.K.
Researchers at Stony Brook University School of Dental Medicine and Ortek Therapeutics developed the chocolate-flavored, sugar-free soft chew after decades of research. It helps maintain healthy teeth by supporting the normal pH levels that exist on tooth surfaces while coating the teeth with a mineral source, according to the company.
"We recommend two per day, in morning after breakfast and at bedtime after brushing and flossing," Mitchell Goldberg, president of Ortek, said in an interview with DrBicuspid.com. He also noted their potential benefits for people with xerostomia.
"The ingredients in BasicBites mirror the vital nutrients that are found in healthy saliva," said Israel Kleinberg, DDS, PhD, DSc, a distinguished professor in the department of oral biology and pathology and the director of the division of translational oral biology at Stony Brook, in a press release. "We spent decades analyzing and literally taking apart saliva, and we eventually solved the puzzle of the protective and natural benefits of saliva."
“We spent decades analyzing and literally taking apart saliva.”
Dr. Kleinberg was the founding chairman of the department of oral biology at Stony Brook during the early 1970s, the first of its kind in the U.S., Goldberg noted. "He is considered a pioneer of oral biology in the U.S., if not the world," he said. In the course of his saliva research, Dr. Kleinberg found that the amino acid arginine supports the sustained base or alkali production on the surfaces of the teeth.
That understanding became the foundation of Ortek's AlkaGen Technology in BasicBites, which consist of two main ingredients that work together: arginine bicarbonate and calcium carbonate.
"We found that the technology had a dual mechanism centered around pH response," Goldberg said. "Calcium helps with remineralization when the mouth is in a pH-neutral state, around 7." The calcium can coat and support healthy tooth structure in that environment.
This mechanical function was noted by researchers around 2000, Goldberg said, when it was observed that calcium plugged dental tubules when pH was neutral in the mouth.

"Arginine and calcium had almost an adhesive quality," he said. "So we developed Rx products -- like a prophy paste that had a sensitivity claim. It was not a drug, but a purely mechanical device so a hygienist could apply it."
They also developed a fluoride-free dentifrice call DenClude, which was sold to Colgate-Palmolive in 2008. Colgate now has a product sold in the U.S. called Colgate Sensitive Pro-Relief Desensitizing paste, an in-office treatment only available to dental professionals.
Meanwhile, a similar product that utilizes the same technology is available to consumers in the U.K. Colgate's line includes a dentifrice, a version for children, and a mouthwash. The company has done "eight years of clinical research involving 14,000 people," according to its website.
One such study, published in the Journal of Dentistry, compared a dentifrice with 1.5% arginine, an insoluble calcium compound, and 1,450 parts per million of fluoride, as sodium monofluorophosphate, and a control dentifrice containing fluoride (August 2013, Vol. 41:suppl 2, pp. S29-S34). The researchers tested each one's ability to arrest and reverse early coronal caries lesions in children using quantitative light-induced fluorescence and found that the experimental dentifrice "provided statistically significant superior efficacy."